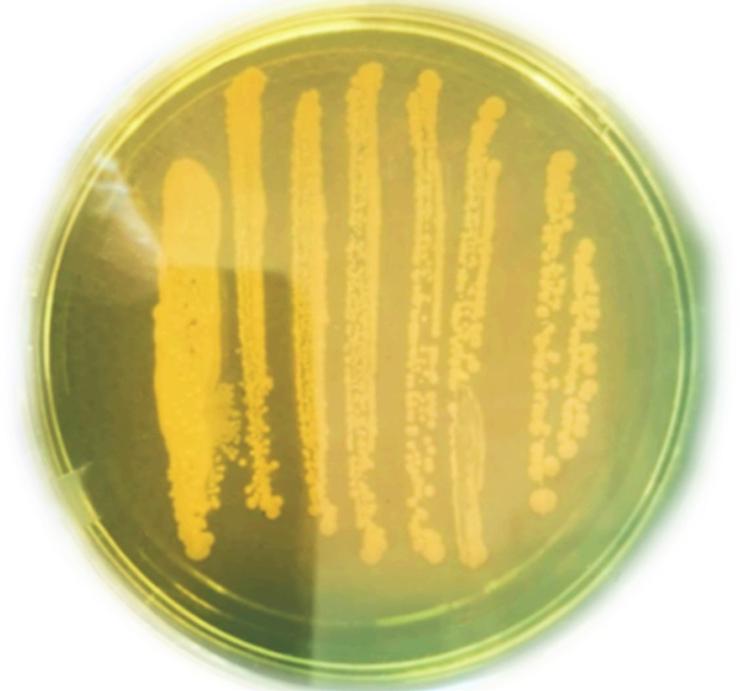
An example of Vibrio cholerae grown on TCBS media.

Fig. 1.
Fig. 2.

Fig. 3.

Fig. 4.

Fig. 5.

Percentage distribution of diagnosed cases according to age groups and gender for both June and July 2022_
| Age group (years) | Gender | June | July | ||
|---|---|---|---|---|---|
| Number of cases | % | Number of cases | % | ||
| < 1 | Male | 0 | 0.00% | 0 | 0.00% |
| Female | 0 | 0.00% | 0 | 0.00% | |
| 1–4 | Male | 0 | 0.00% | 0 | 0.00% |
| Female | 1 | 0.00% | 0 | 0.00% | |
| 5–9 | Male | 4 | 0.10% | 0 | 0.00% |
| Female | 0 | 0.00% | 0 | 0.00% | |
| 10–14 | Male | 9 | 0.30% | 3 | 0.20% |
| Female | 25 | 0.70% | 15 | 1.20% | |
| 15–19 | Male | 149 | 4.30% | 66 | 5.20% |
| Female | 217 | 6.20% | 95 | 7.40% | |
| 20–44 | Male | 1,156 | 33.30% | 412 | 32.20% |
| Female | 980 | 28.20% | 379 | 29.60% | |
| 45–64 | Male | 340 | 9.80% | 90 | 7.00% |
| Female | 381 | 11.00% | 131 | 10.20% | |
| > 65 | Male | 97 | 2.80% | 25 | 2.00% |
| Female | 115 | 3.30% | 64 | 5.00% | |
| Total cases | 3,474 | 100% | 1,280 | 100% | |